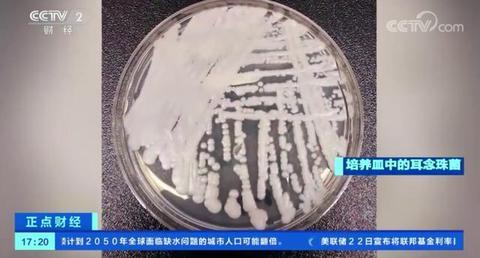
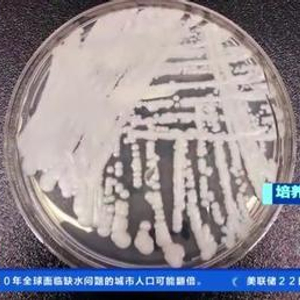

据央视新闻客户端报道,当地时间3月20日,美国疾病控制和预防中心表示,耳念珠菌正在以“惊人的速度”传播,目前已遍布美国一半以上的州,成为紧迫的公共卫生威胁。
什么是耳念珠菌?
耳念珠菌是一种近年来新发现的酵母菌,因为其最先从外耳道发现,所以称为耳念珠菌。此类真菌具有极端生存和繁殖能力,2009年首次在日本发现,也被成为“超级真菌”。
近年来,耳念珠菌在全球30多个国家有报道,目前该真菌在美国为较为严重的流行传播。
“耳念珠菌作为一类重要的感染性病原微生物,能够广泛定植于黏膜和皮肤上。”北京协和医院耳鼻喉科主任医师蒋子栋介绍,由于免疫抑制药物、抗生素过度广泛使用变异出了新的真菌,耳念珠菌耐药性高,对抗真菌药物不敏感,已成为紧迫的公共卫生威胁。
哪些人群容易被感染?
据浙大二院感染性疾病科副主任医师吴丹丹介绍,耳念珠菌感染主要见于医院内聚集感染,因为医院会使用各种抗生素,能存活下来的都是耐药性极强的病菌,它们像伺机作案的罪犯一样定植于人体,时刻寻找作案的时机。免疫功能低下者,以及糖尿病患者和其他慢性疾病患者,是感染的高风险人群。健康人群通常不会感染,大家无需过度恐慌。
此外,美疾控中心介绍说,患重病、接受侵入性医疗设备治疗以及长期或频繁在医疗保健机构住院的人群感染风险增加。它可引发严重的侵入性感染,包括血流感染、伤口感染和耳部感染等。
死亡率高吗?
据美国疾病控制和预防中心(CDC)发布信息,近一半感染了耳念珠菌的患者会在90天内死亡,而且在受感染的住院病人中,估计有30%至70%的人最终会死亡。
据央视新闻客户端消息,从2019年到2020年,美国的感染人数增加了59%,达到756人,2021年感染人数增加了95%,达到1471人,2022年感染人数进一步上升,达到2377人。2019年至2021年,全美共有17个州首次发现耳念珠菌病例。
美疾控中心流行病学家梅根·莱曼表示,耳念珠菌病例数的快速增长及其传播地域范围的扩大令人担忧。

我国有感染病例吗?
2009年,耳念珠菌在日本首次被发现,通过回顾性检测,1996年它就曾在韩国出现。2018年,北京大学人民医院一位肾病综合征患者的肺泡灌洗液中检测出耳念珠菌,这是我国首例耳念珠菌感染病例。
吴丹丹说,目前我国只有少量的耳念珠菌感染病例,且基本发生在院内。据了解,截至2020年8月,中国公开报道的耳念珠菌感染病例报道数量为25例。
如何避免被感染?
接触传播是耳念珠菌引起医院感染的主要原因,一旦发生耳念珠菌医院感染,极易在病区,甚至医院内播散。
蒋子栋提醒,“对于进入过疫区后回国的人,回国前、回国后,一定要认真清洗身体与衣物,并进行消毒,同时,不要接触有免疫力缺陷和免疫力低下的人,最好不要到医院看病人。”
此外,对于预防耳念球菌早诊断非常重要。蒋子栋介绍,如果临床上,医生发现耳道出现感染、并伴有不明原因的高热、腹泻、呼吸困难的患者,一定要其转到上级专业检查机构进一步检查,不要误判、漏判,发现疑似患者,要采取相应隔离防控措施,才能避免大规模传播。